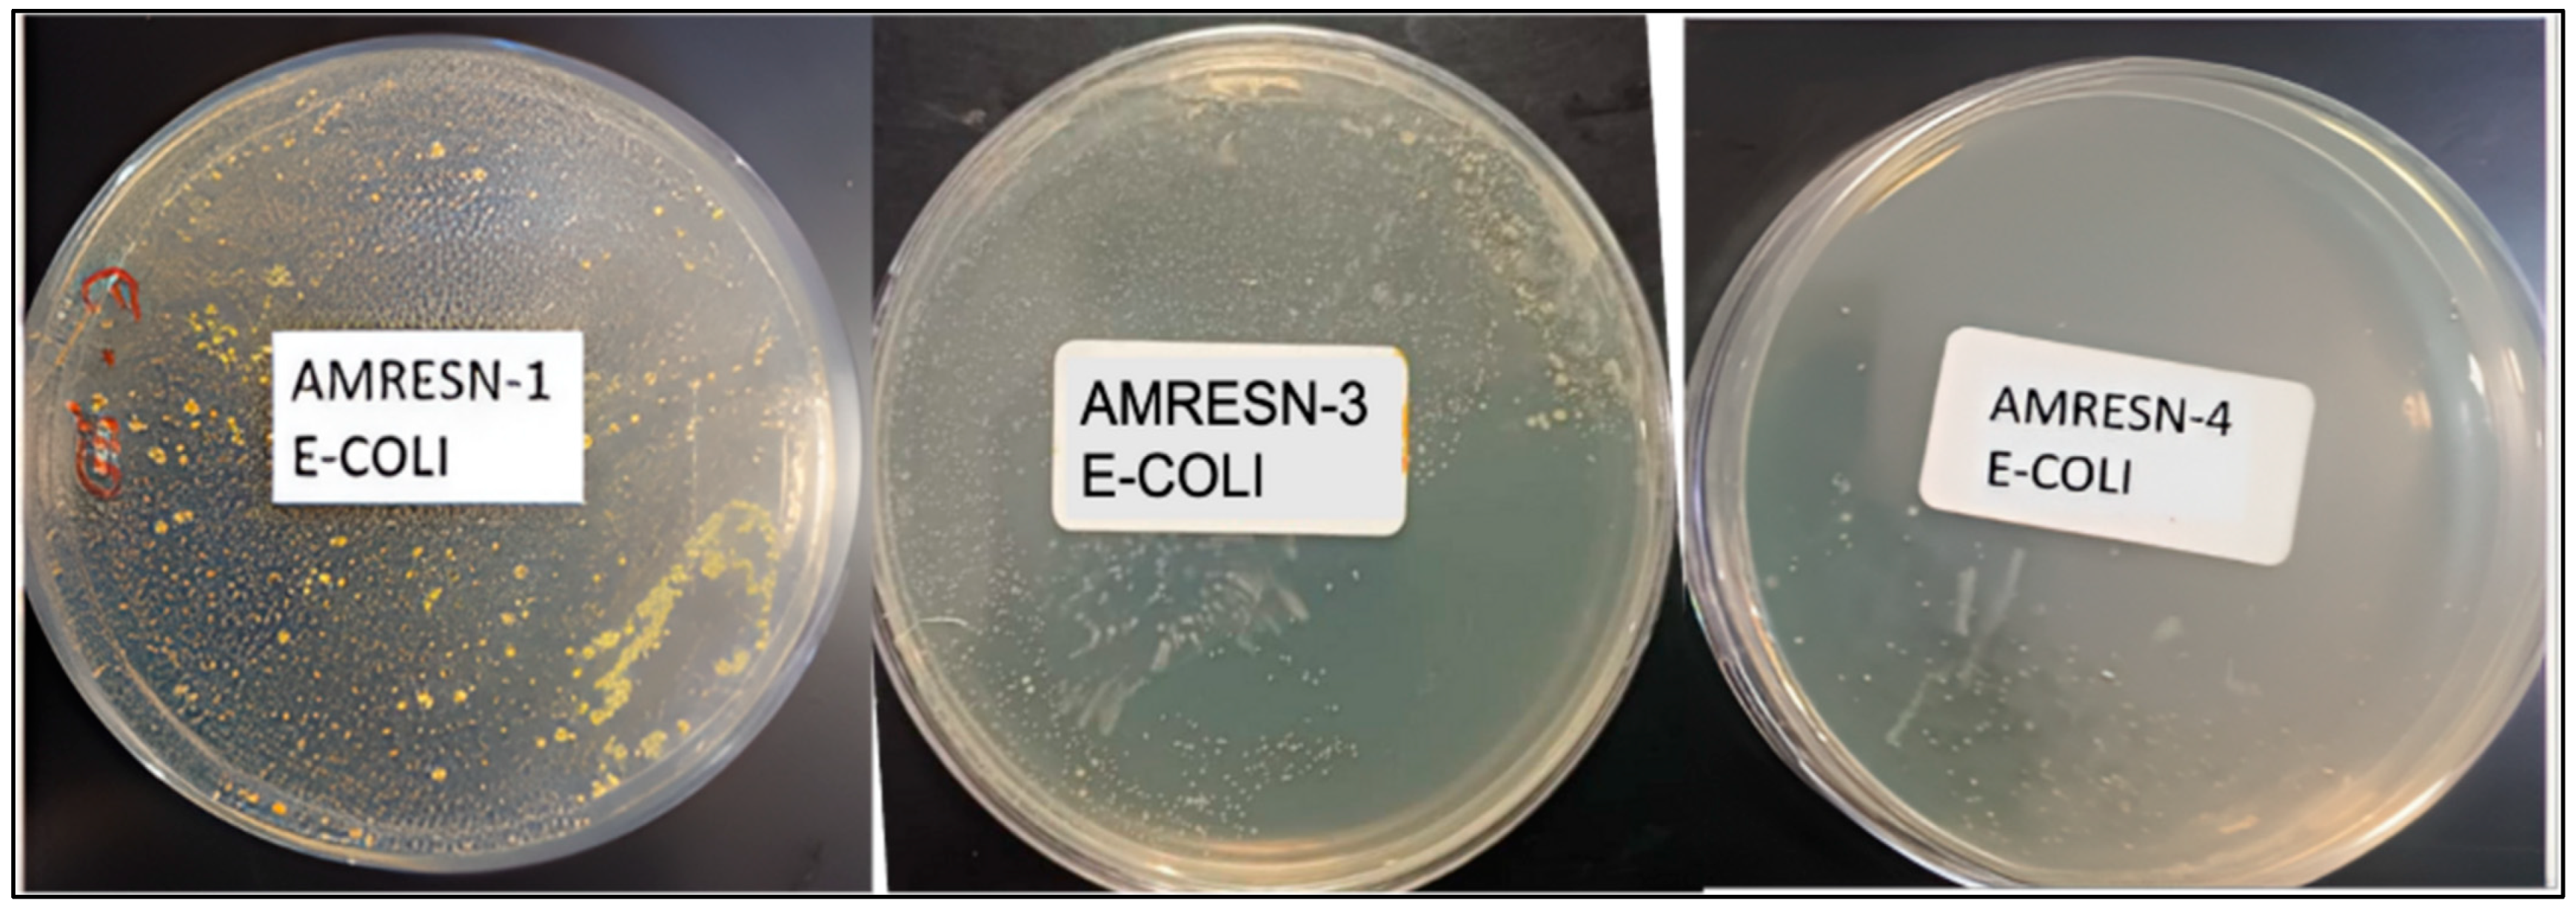
Coatings 15 00370 g015
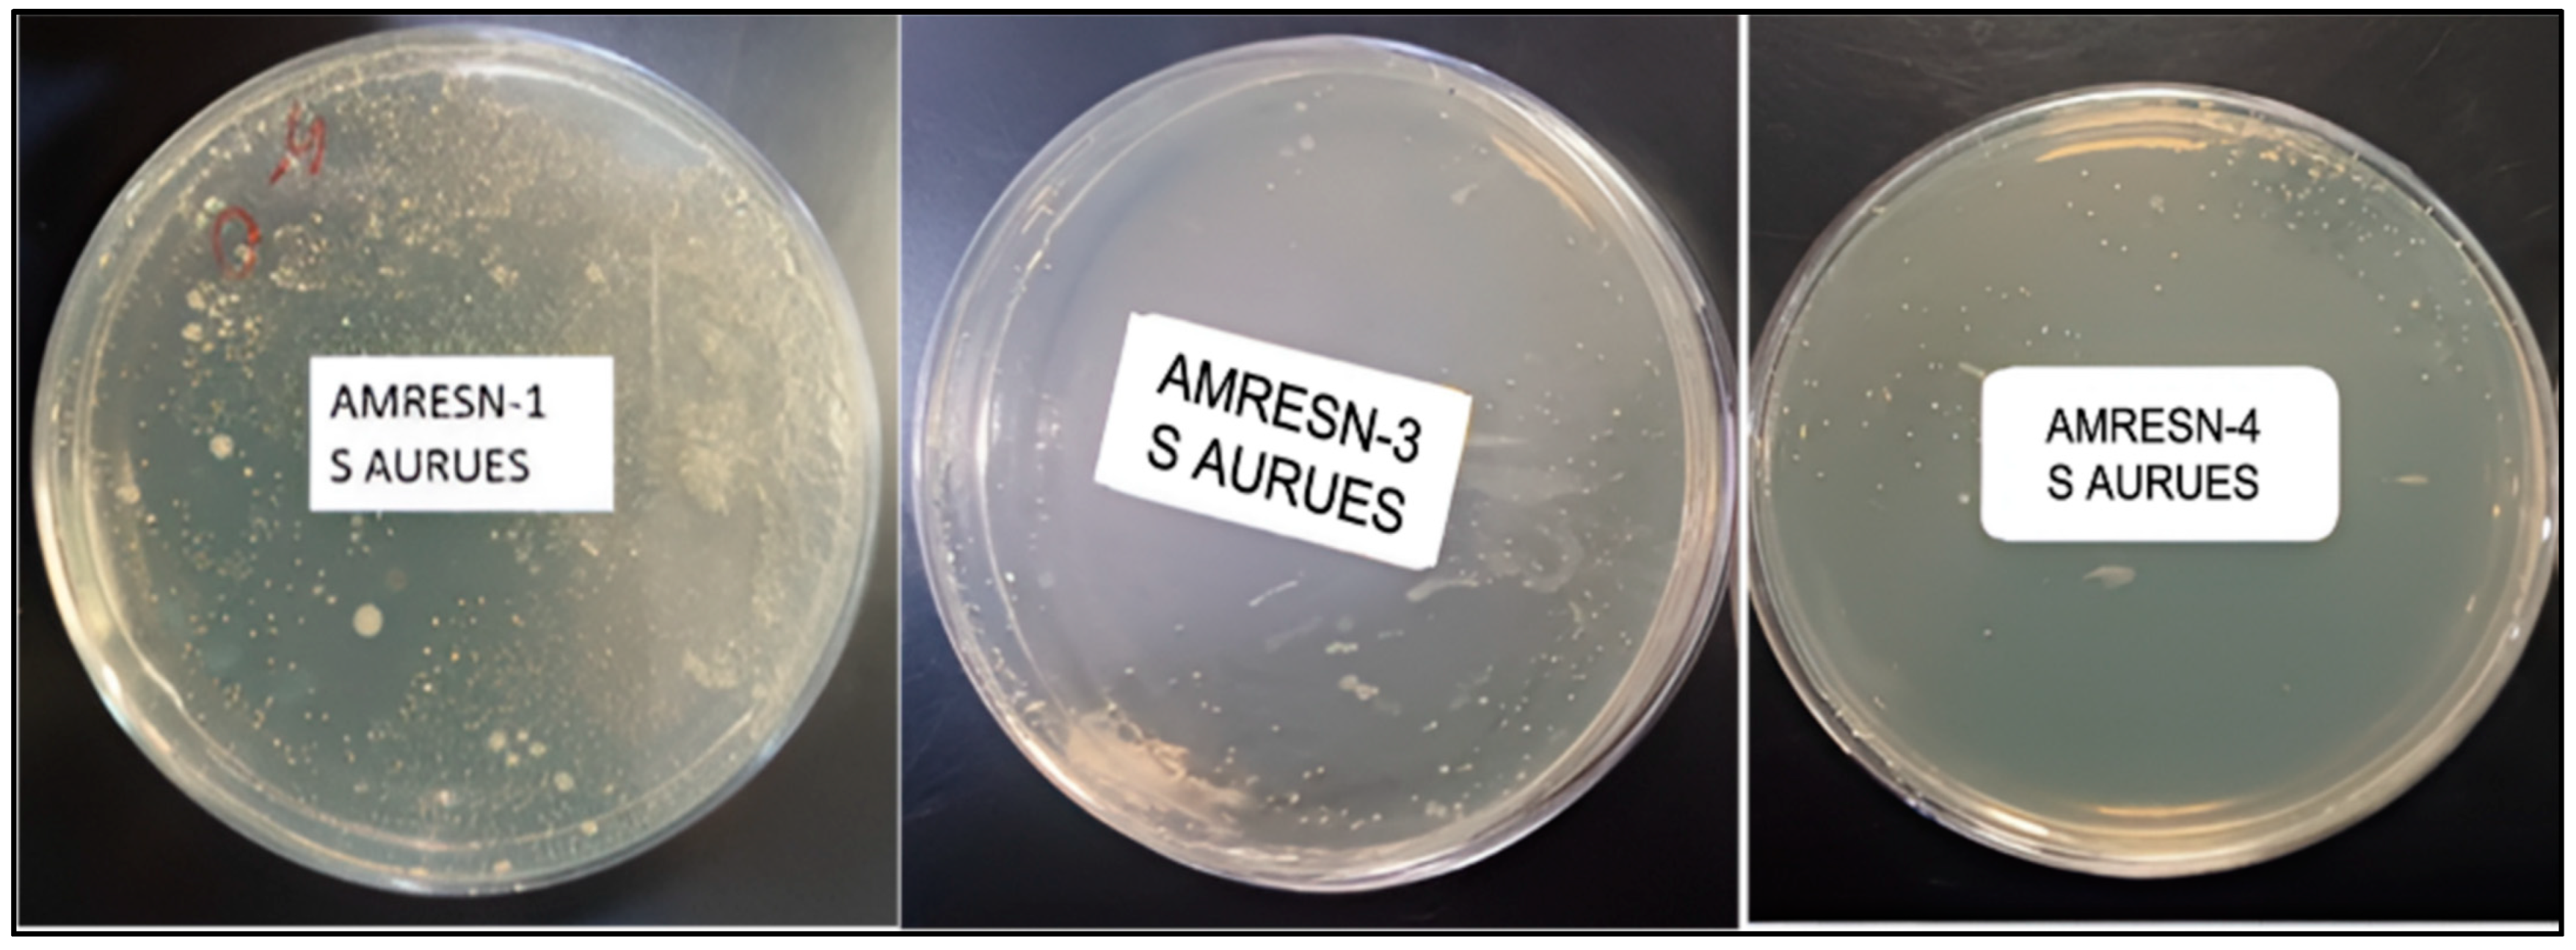
Coatings 15 00370 g016

Bio-Based Alkyd–Polyesteramide–Polyurethane Coatings from Castor, Neem, and Karanja Oils with Inherent Antimicrobial Properties for Enhanced Hygiene
Abstract
1. Introduction
2. Materials and Methods
3. Experimental Section
3.1. Alkyd Resin Preparation
3.2. Synthesis of Castor-Oil-Based Monoglyceride (COMG)
3.3. Preparation of Castor-Oil-Based Alkyd Resin (COAR)
3.4. Polyesteramide Resin
3.5. Synthesis of Neem Oil Fatty Diethanolamide (NOFA)
3.6. Preparation of Neem Oil Polyesteramide Resin (NOPA)
3.7. Development of PU Coatings
4. Method of Characterization
4.1. Instrumentation Techniques
4.2. End Group Analysis
4.2.1. Acid Value
4.2.2. Amine Value
4.2.3. Hydroxyl Value
4.3. Cured Film Characterization
4.4. Antimicrobial Testing
4.5. Statistical Analysis
5. Results
5.1. Physicochemical Characteristics
5.2. FTIR Analysis of Castor Oil Alkyd, Neem, and Karanja Oil Polyesteramide Polyols
5.3. 1H NMR Analysis of Alkyd Resin, Fatty Amides, and Polyesteramide Polyols
5.4. Water Absorption Properties of Coatings
5.5. Mechanical Properties of Coatings
5.6. DSC Thermograms of PU Coatings
5.7. Thermo-Gravimetric Analysis of PU Coatings
5.8. Chemical Resistance Properties of PU Coatings
5.9. Solvent Resistance Properties of PU Coatings
5.10. Antimicrobial Testing
5.11. Bio-Based Content
6. Conclusions
Author Contributions
Funding
Institutional Review Board Statement
Informed Consent Statement
Data Availability Statement
Conflicts of Interest
References
- Kramer, A.; Assadian, O. Survival of microorganisms on inanimate surfaces. In Use of Biocidal Surfaces for Reduction of Healthcare Acquired Infections; Springer International Publishing: Berlin/Heidelberg, Germany, 2014; pp. 7–26. [Google Scholar]
- Kalb, L.; Bäßler, P.; Schneider-brachert, W.; Eckl, D.B. Antimicrobial Photodynamic Coatings Reduce the Microbial Burden on Environmental Surfaces in Public Transportation—A Field Study in Buses. Int. J. Environ. Res. Public Health 2022, 19, 2325. [Google Scholar] [CrossRef]
- Ehrenberg, R. Urban microbes come out of the shadows. Nature 2015, 522, 399–400. [Google Scholar] [CrossRef] [PubMed]
- Sati, A.; Ranade, T.N.; Mali, S.N.; Ahmad Yasin, H.K.; Pratap, A. Silver Nanoparticles (AgNPs): Comprehensive Insights into Bio/Synthesis, Key Influencing Factors, Multifaceted Applications, and Toxicity—A 2024 Update. ACS Omega 2025, 10, 7549–7582. [Google Scholar] [CrossRef]
- Muñoz-Bonilla, A.; Fernández-García, M. Polymeric materials with antimicrobial activity. Prog. Polym. Sci. 2012, 37, 281–339. [Google Scholar] [CrossRef]
- Jalvo, B.; Faraldos, M.; Bahamonde, A.; Rosal, R. Antimicrobial and antibiofilm efficacy of self-cleaning surfaces functionalized by TiO2 photocatalytic nanoparticles against Staphylococcus aureus and Pseudomonas putida. J. Hazard. Mater. 2017, 340, 160–170. [Google Scholar] [CrossRef]
- Wang, G.; Wen, S.; Qian, S.; Wang, J.; Wang, C.; Chen, Y. Synthesis of novel nano hyperbranched polymer resin and its corrosion resistance in coatings. Prog. Org. Coat. 2020, 140, 105496. Available online: https://www.sciencedirect.com/science/article/pii/S0300944019314961 (accessed on 28 November 2024). [CrossRef]
- Feng, G.; Ma, Y.; Zhang, M.; Jia, P.; Hu, L.; Liu, C.; Zhou, Y. Polyurethane-coated urea using fully vegetable oil-based polyols: Design, nutrient release and degradation. Prog. Org. Coat. 2019, 133, 267–275. Available online: https://www.sciencedirect.com/science/article/pii/S0300944018313195 (accessed on 28 November 2024). [CrossRef]
- Nagtode, V.S.; Cardoza, C.; Yasin, H.K.A.; Mali, S.N.; Tambe, S.M.; Roy, P.; Singh, K.; Goel, A.; Amin, P.D.; Thorat, B.R.; et al. Green Surfactants (Biosurfactants): A Petroleum-Free Substitute for Sustainability—Comparison, Applications, Market, and Future Prospects. ACS Omega 2023, 8, 11674–11699. [Google Scholar] [CrossRef]
- Ranade, T.; Sati, A.; Pratap, A.; Mali, S.N. Curcumin-Integrated Biopolymer Films for Active Packaging: Current Trends and Future Directions; Chemical Papers; Springer Science and Business Media Deutschland GmbH: Berlin/Heidelberg, Germany, 2025. [Google Scholar]
- Mali, S.N.; Pandey, A. Development of curcumin integrated smart pH indicator, antibacterial, and antioxidant waste derived Artocarpus lakoocha starch-based packaging film. Int. J. Biol. Macromol. 2024, 275, 133827. Available online: https://www.sciencedirect.com/science/article/pii/S0141813024046324 (accessed on 28 November 2024). [CrossRef]
- Seniha Güner, F.; Yağcı, Y.; Tuncer Erciyes, A. Polymers from triglyceride oils. Prog. Polym. Sci. 2006, 31, 633–670. Available online: https://www.sciencedirect.com/science/article/pii/S0079670006000542 (accessed on 28 November 2024). [CrossRef]
- Lligadas, G.; Ronda, J.C.; Galià, M.; Cádiz, V. Renewable polymeric materials from vegetable oils: A perspective. Mater. Today 2013, 16, 337–343. Available online: https://www.sciencedirect.com/science/article/pii/S1369702113002940 (accessed on 28 November 2024). [CrossRef]
- Xia, Y.; Larock, R.C. Vegetable oil-based polymeric materials: Synthesis, properties, and applications. Green Chem. 2010, 12, 1893–1909. [Google Scholar] [CrossRef]
- Dizman, C.; Cerrahoğlu Kaçakgıl, E. Alkyd resins produced from bio-based resources for more sustainable and environmentally friendly coating applications. Turk. J. Chem. 2023, 47, 1–23. [Google Scholar] [CrossRef] [PubMed]
- Godfrey, O.O.; Ifijen, I.H.; Mohammed, F.U.; Aigbodion, A.I.; Ikhuoria, E.U. Alkyd resin from rubber seed oil/linseed oil blend: A comparative study of the physiochemical properties. Heliyon 2019, 5, e01621. [Google Scholar]
- Chiplunkar, P.; Pratap, A. Utilization of sunflower acid oil for synthesis of alkyd resin. Prog. Org. Coat. 2016, 93, 61–67. [Google Scholar]
- Xu, Y.; Petrovic, Z.; Das, S.; Wilkes, G.L. Morphology and properties of thermoplastic polyurethanes with dangling chains in ricinoleate-based soft segments. Polymer 2008, 49, 4248–4258. [Google Scholar]
- Rodriguez-Galan, A.; Franco, L.; Puiggali, J. Degradable poly(ester amide)s for biomedical applications. Polymers 2011, 3, 65–99. [Google Scholar]
- Ranganathan, P.; Chen, C.W.; Rwei, S.; Lee, Y.H.; Ramaraj, S.K. Methods of Synthesis, Characterization and Biomedical Applications of Biodegradable Poly(Ester Amide)s—A Review. Polym. Degrad. Stab. 2020, 181, 109323. [Google Scholar] [CrossRef]
- Patel, V.R.; Dumancas, G.G.; Viswanath, L.C.K.; Maples, R.; Subong, B.J.J. Castor oil: Properties, uses, and optimization of processing parameters in commercial production. Lipid Insights 2016, 9, 1–12. [Google Scholar] [CrossRef]
- Doke, R.B.; Bhalerao, M.S.; Paraskar, P.M.; Patil, P.S.; Kulkarni, R.D. Energy-efficient sonochemical extraction of bioactive compound karanjin from Pongamia pinnata leaves. Chem. Pap. 2021, 75, 4935–4947. [Google Scholar] [CrossRef]
- Dunford NTurgut. Food and Industrial Bioproducts and Bioprocessing; Wiley-Blackwell: Hoboken, NJ, USA, 2012; 396p. [Google Scholar]
- Devansh Patil, P.; Pinjari, D.V. Oil-based epoxy and their composites: A sustainable alternative to traditional epoxy. J. Appl. Polym. Sci. 2024, 141, e55560. [Google Scholar] [CrossRef]
- Chaudhari, A.; Kulkarni, R.; Mahulikar, P.; Sohn, D.; Gite, V. Development of PU coatings from neem oil based alkyds prepared by the monoglyceride route. JAOCS J. Am. Oil Chem. Soc. 2015, 92, 733–741. [Google Scholar] [CrossRef]
- Bhat, S.S. Neem—A Green Treasure. Electron. J. Biol. 2008, 4, 102–111. [Google Scholar]
- Rinaldi, F.; Hanieh, P.N.; Longhi, C.; Carradori, S.; Secci, D.; Zengin, G.; Ammendolia, M.G.; Mattia, E.; Del Favero, E.; Marianecci, C.; et al. Neem oil nanoemulsions: Characterisation and antioxidant activity. J. Enzym. Inhib. Med. Chem. 2017, 32, 1265–1273. [Google Scholar] [CrossRef]
- Aneesa, N.; Gayathri, J. Beneficial effects of neem oil—An updated review. J. Pharm. Sci. Res. 2016, 8, 756–758. [Google Scholar]
- Tiwari, S. Traditional Utilization and Pharmacological Properties of Medicinal Plants Volume-2 Chief Editor; Scripown Publications: Delhi, India, 2023. [Google Scholar]
- Ayurveda, S. Karanj (Pongamia Pinnata)—An Ayurvedic and Modern Overview Shifali Thakur, Hemlata Kaurav, Gitika Chaudhary. Asian J. Pharm. Clin. Res. 2021, 14, 2021. [Google Scholar] [CrossRef]
- Mishra, P.; RS, S.K.; Jerobin, J.; Thomas, J.; Mukherjee, A.; Chandrasekaran, N. Study on antimicrobial potential of neem oil nanoemulsion against Pseudomonas aeruginosa infection in Labeo rohita. Biotechnol. Appl. Biochem. 2014, 61, 611–619. [Google Scholar]
- Wylie, M.; Merrell, D. The Antimicrobial Potential of the Neem Tree Azadirachta indica. Front. Pharmacol. 2022, 13, 891535. [Google Scholar]
- Ghosh, V.; Sugumar, S.; Mukherjee, A.; Chandrasekaran, N. Neem (Azadirachta indica) Oils. In Essential Oils in Food Preservation, Flavor and Safety; Elsevier: Amsterdam, The Netherlands, 2015; pp. 593–599. [Google Scholar]
- Alagi, P.; Hong, S.C. Vegetable oil-based polyols for sustainable polyurethanes. Macromol. Res. 2015, 23, 1079–1086. [Google Scholar]
- Finnigan, B.; Martin, D.; Halley, P.; Truss, R.; Campbell, K. Morphology and properties of thermoplastic polyurethane composites incorporating hydrophobic layered silicates. J. Appl. Polym. Sci. 2005, 97, 300–309. [Google Scholar]
- Parcheta, P.; Głowińska, E.; Datta, J. Effect of bio-based components on the chemical structure, thermal stability and mechanical properties of green thermoplastic polyurethane elastomers. Eur. Polym. J. 2020, 123, 109422. [Google Scholar] [CrossRef]
- Asensio, M.; Ferrer, J.F.; Nohales, A.; Culebras, M.; Gómez, C.M. The Role of Diisocyanate Structure to Modify Properties of Segmented Polyurethanes. Materials 2023, 16, 1633. [Google Scholar] [CrossRef]
- Luo, S.G.; Tan, H.M.; Zhang, J.G.; Wu, Y.J.; Pei, F.K.; Meng, X.H. Catalytic mechanisms of triphenyl bismuth, dibutyltin dilaurate, and their combination in polyurethane-forming reaction. J. Appl. Polym. Sci. 1997, 65, 1217–1225. [Google Scholar] [CrossRef]
- Hagiwara, K.; Kanato, H.; Bessho, T. Method for Producing Resin Composition Used for Paint. U.S. Patent No. 6,630,523 B2, 7 October 2003. [Google Scholar]
- Zhang, Q.; Wu, J.; Ma, P.; Cai, J.; Zhang, Y. Acid Value Determination and Pre-Esterification of Crude Euphorbia lathyris, L. Oil. World J. Eng. Technol. 2015, 03, 70–75. [Google Scholar] [CrossRef]
- Villani, M.; Bertoglio, F.; Restivo, E.; Bruni, G.; Iervese, S.; Arciola, C.R.; Carulli, F.; Iannace, S.; Bertini, F.; Visai, L. Polyurethane-based coatings with promising antibacterial properties. Materials 2020, 13, 4296. [Google Scholar] [CrossRef]
- Wiegand, C.; Völpel, A.; Ewald, A.; Remesch, M.; Kuever, J.; Bauer, J.; Griesheim, S.; Hauser, C.; Thielmann, J.; Tonndorf-Martini, S. Critical physiological factors influencing the outcome of antimicrobial testing according to ISO 22196/JIS Z 2801. PLoS ONE 2018, 13, e0194339. [Google Scholar] [CrossRef] [PubMed]
- Merdas, I.; Tcharkhtchi, A.; Thominette, F.; Verdu, J.; Dean, K.; Cook, W. Water absorption by uncrosslinked polymers, networks and IPNs having medium to high polarity. Polymer 2002, 43, 4619–4625. Available online: https://www.sciencedirect.com/science/article/pii/S0032386102002677 (accessed on 20 November 2023). [CrossRef]
- Ma, Q.; Liu, X.; Zhang, R.; Zhu, J.; Jiang, Y. Synthesis and properties of full bio-based thermosetting resins from rosin acid and soybean oil: The role of rosin acid derivatives. Green Chem. 2013, 15, 1300–1310. [Google Scholar] [CrossRef]
- Mishra, V.K.; Desai, J.; Patel, K.I. (UV/Oxidative) dual curing polyurethane dispersion from cardanol based polyol: Synthesis and characterization. Ind. Crop. Prod. 2018, 111, 165–178. Available online: https://api.semanticscholar.org/CorpusID:103711206 (accessed on 28 November 2023). [CrossRef]
- Nadim, E.; Paraskar, P.; Murphy, E.J.; Hesabi, M.; Major, I. Sustainable polyurethane coatings based on functional Camelina oil-based polyols. Ind. Crop. Prod. 2023, 204, 117274. Available online: https://www.sciencedirect.com/science/article/pii/S0926669023010397 (accessed on 28 November 2023). [CrossRef]
- Alagi, P.; Ghorpade, R.; Jang, J.H.; Patil, C.; Jirimali, H.; Gite, V.; Hong, S.C. Controlled Hydroxyl Functionality of Soybean Oil-Based Polyols for Polyurethane Coatings with Improved Anticorrosion Properties. Macromol. Res. 2018, 26, 696–703. [Google Scholar] [CrossRef]
- Patil, D.M.; Phalak, G.A.; Mhaske, S.T. Design and synthesis of bio-based UV curable PU acrylate resin from itaconic acid for coating applications. Des. Monomers Polym. 2017, 20, 269–282. [Google Scholar] [PubMed]
- Chattopadhyay, D.K.; Webster, D.C. Thermal stability and flame retardancy of polyurethanes. Prog. Polym. Sci. 2009, 34, 1068–1133. [Google Scholar]
- Patil, C.K.; Jung, D.W.; Jirimali, H.D.; Baik, J.H.; Gite, V.V.; Hong, S.C. Nonedible vegetable oil-based polyols in anticorrosive and antimicrobial polyurethane coatings. Polymers 2021, 13, 3149. [Google Scholar] [CrossRef] [PubMed]
- Saweres-Argüelles, C.; Ramírez-Novillo, I.; Vergara-Barberán, M.; Carrasco-Correa, E.J.; Lerma-García, M.J.; Simó-Alfonso, E.F. Skin absorption of inorganic nanoparticles and their toxicity: A review. Eur. J. Pharm. Biopharm. 2022, 182, 128–140. [Google Scholar] [CrossRef]

| Oil | Fatty Acid Profile | Key Components | Role Current Research |
|---|---|---|---|
| Castor Oil | 90% Ricinoleic, 4% Linoleic, 3% Oleic, 1% Stearic, <1% Linolenic | Hydroxyl functionality of ricinoleic acid, oxidative stability, prevents peroxide formation | To provide high crosslinking density with hardners. The long aliphatic chains provide good hydrophobic characterisics |
| Neem Oil | 50%–60% Oleic, 13%–15% Palmitic, 14%–19% Stearic, 8%–16% Linoleic, 1%–3% Arachidic | Azadirachtin, gedunin, isomargolonone, margolone, margolonone, nimbidin, nimbin, nimbolide, salannin | Antibacterial, antifungal, antifertility, immunostimulant, antipyretic, acaricidal, antimicrobial coatings |
| Karanja Oil | 11.6% Palmitic, 51.5% Oleic, 16% Linoleic | Karanjin, pongamol, beta-sitosterol, linoleic acid | Antibacterial, antifungal, antimicrobial surface coatings, human healthcare applications |
| Category | Variable | Details |
|---|---|---|
| Independent Variables | Concentration of COAR | Castor-oil-based alkyd resin |
| Concentration of NOPA | Neem-oil-based polyesteramide resin | |
| Concentration of KOPA | Karanja-oil-based polyesteramide resin | |
| Concentration of HDI Isocyanate | Hardener | |
| Concentration of MDI Isocyanate | Hardener | |
| Dependent Variables | Mechanical Properties | |
| Adhesion Strength | Cross-cut adhesion test, pull-off test | |
| Scratch Resistance | Pencil hardness test | |
| Flexibility | Conical Mandrel test | |
| Impact Hardness | Impact hardness test | |
| Thermal Properties | ||
| Glass Transition Temperature | Differential scanning calorimetry (DSC). | |
| Thermal Stability | Thermogravimetric analysis (TGA) | |
| Chemical Resistance | ||
| Solvent Resistance | Immersion tests in different chemicals | |
| Acid/Alkali Resistance | Resistance against acidic and alkaline environments | |
| Surface Properties | ||
| Contact Angle | Hydrophobicity/hydrophilicity | |
| Drying Time | Time taken for complete drying | |
| Surface Roughness | SEM analysis | |
| Gloss Test | Reflectivity measurements | |
| Barrier Properties | ||
| Water Absorption | ASTM D570 | |
| Curing and Crosslinking Efficiency | ||
| Gel Content | Percentage of insoluble fraction in solvent extraction test, indicating degree of crosslinking | |
| Crosslink Density | Measurement of crosslinking efficiency | |
| Antimicrobial Efficacy | ||
| Antimicrobial Activity | JIS Z 2801 assay | |
| Control Variables | Coating Technique | Brush coating |
| Number of Coats | 1 | |
| Temperature | 25 °C | |
| Mixing Time | 2 min | |
| Solvent Volume | Xylene, MEK, and acetone in a 50:25:25 w/v ratio with respect to total resin weight | |
| Resin Formulation | Hardner Isocyanates (Weight% of Resin) | ||||
|---|---|---|---|---|---|
| PU COATING | COAR (wt%) | NOPA (wt%) | KOPA (wt%) | HDI (wt%) | MDI (wt%) |
| AMRESN-1 | 100 | 0 | 0 | 46.6 | - |
| AMRESN-2 | 90 | 5 | 5 | 36 | 2 |
| AMRESN-3 | 80 | 10 | 10 | 26 | 6 |
| AMRESN-4 | 60 | 20 | 20 | 21 | 9.6 |
| End Group | Acid Value (mg of KOH g−1 of Sample) | Hydroxyl Value (mg of KOH g−1 of Sample) | Conversion (%) |
|---|---|---|---|
| COMG monoglyceride | 5 | 320 | 99 |
| NOFA fatty amide | 15 | 270 | 98 |
| KOFA fatty amide | 16 | 260 | 97 |
| End Group | Acid Value (mg of KOH g−1 of Sample) | Hydroxyl Value (mg of KOH g−1 of Sample) | Equivalent Weight (gm) |
|---|---|---|---|
| COAR alkyd resin | 2.5 | 260 | 215.76 |
| NOPA polyesteramide polyol | 4.5 | 184.3 | 304.39 |
| KOPA polyesteramide polyols | 6.2 | 182.2 | 307.90 |
| Sample | Surface Drying (min) | Tack Free (min) | Hard Drying (h) |
|---|---|---|---|
| AMRESN-1 | 15 | 45 | 6 |
| AMRESN-2 | 6 | 60 | 7 |
| AMRESN-3 | 18 | 75 | 7.1 |
| AMRESN-4 | 19 | 80 | 7.5 |
| Property | AMRESN-1 | AMRESN-2 | AMRESN-3 | AMRESN-4 |
|---|---|---|---|---|
| Gloss [°] | 133 | 128 | 122 | 119 |
| Thickness [μm] [%] | 51.11 | 52.21 | 47 | 47 |
| Flexibility test (conical mandrel) | Pass | Pass | Pass | Pass |
| Scratch hardness [kg] | 4.3 | 4.4 | 4.8 | 5.2 |
| Impact resistance [kg/cm] | 90 | 98 | 110 | 115 |
| Pencil hardness | 3H | 3H | 4H | 4H |
| Contact angle [°] | 102.7 | 103.1 | 104.2 | 104.9 |
| Gel content [%] | 98.15 | 98.3 | 98.34 | 98.4 |
| Water absorption [%] | 0.25 | 0.24 | 0.22 | 0.21 |
| Sample | Solvent Rub Test | Acid-Alkali Resistance (5% HCl, 5% NaOH) | |
|---|---|---|---|
| Methyl Ethyl Ketone | Xylene | ||
| AMRESN-1 | Z | Y | Y |
| AMRESN-2 | Y | X | X |
| AMRESN-3 | X | X | X |
| AMRESN-4 | X | X | X |
| Existing Antimicrobial Coatings | Bio-Based Antimicrobial Coatings (AMRESN) |
|---|---|
| Derived from non-biodegradable petrochemical sources. | Derived from natural sources that are biodegradable. |
| Antimicrobial properties can only be achieved by using additives. | Inherent antimicrobial properties. |
| Coatings encapsulated with nanoparticles can penetrate the human skin and have toxic effects [51]. | The coating has bio-based substrates, namely, neem and karanja oil, that provide inherent antimicrobial properties that are safe for human use. |
Disclaimer/Publisher’s Note: The statements, opinions and data contained in all publications are solely those of the individual author(s) and contributor(s) and not of MDPI and/or the editor(s). MDPI and/or the editor(s) disclaim responsibility for any injury to people or property resulting from any ideas, methods, instructions or products referred to in the content. |
© 2025 by the authors. Licensee MDPI, Basel, Switzerland. This article is an open access article distributed under the terms and conditions of the Creative Commons Attribution (CC BY) license (https://creativecommons.org/licenses/by/4.0/).
Share and Cite
Sati, A.; Nandiwdekar, O.; Ratnaparkhi, A.; Doke, R.B.; Pinjari, D.V.; Mali, S.N.; Pratap, A.P. Bio-Based Alkyd–Polyesteramide–Polyurethane Coatings from Castor, Neem, and Karanja Oils with Inherent Antimicrobial Properties for Enhanced Hygiene. Coatings 2025, 15, 370. https://doi.org/10.3390/coatings15040370
Sati A, Nandiwdekar O, Ratnaparkhi A, Doke RB, Pinjari DV, Mali SN, Pratap AP. Bio-Based Alkyd–Polyesteramide–Polyurethane Coatings from Castor, Neem, and Karanja Oils with Inherent Antimicrobial Properties for Enhanced Hygiene. Coatings. 2025; 15(4):370. https://doi.org/10.3390/coatings15040370
Chicago/Turabian StyleSati, Abhinav, Omkar Nandiwdekar, Aditya Ratnaparkhi, Ranjeet B. Doke, Dipak V. Pinjari, Suraj N. Mali, and Amit P. Pratap. 2025. "Bio-Based Alkyd–Polyesteramide–Polyurethane Coatings from Castor, Neem, and Karanja Oils with Inherent Antimicrobial Properties for Enhanced Hygiene" Coatings 15, no. 4: 370. https://doi.org/10.3390/coatings15040370
APA StyleSati, A., Nandiwdekar, O., Ratnaparkhi, A., Doke, R. B., Pinjari, D. V., Mali, S. N., & Pratap, A. P. (2025). Bio-Based Alkyd–Polyesteramide–Polyurethane Coatings from Castor, Neem, and Karanja Oils with Inherent Antimicrobial Properties for Enhanced Hygiene. Coatings, 15(4), 370. https://doi.org/10.3390/coatings15040370

